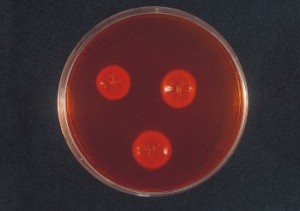
DERMATOPHYTE SELECTIVE CAF. AGAR 1
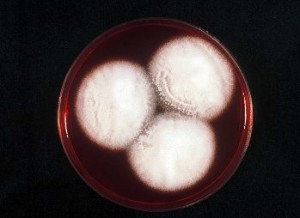
DERMATOPHYTE SELECTIVE CAF. AGAR 2

DTM TAPLIN AGAR DERMATOFITOS PARA DETECCIÓN RÁPIDA DE ESTOS HONGOS DE LAS TIÑAS EN ARENAS DE PLAYAS, MASCOTAS, GRANJAS, UÑAS…
Aislamiento selectivo y detección rápida de hongos dermatófitos (Epidermophyton, Trichophyton, Microsporum…) en arena, piel, plumas, uñas… por viraje del medio de naranja a rojo en 48 horas, mucho antes de la visualización del micelio
COMPOSICIÓN
- Peptona de soja 10,0 g
- Glucosa 40,0 g
- Rojo fenol 0,2 g
- Cloranfenicol 0,5 g
- Agar-Agar 12,0 g
- (Fórmula por litro)
- pH final 5,5 ± 0,2
MANTENGA EL BOTE BIEN CERRADO, EN LUGAR SECO, FRESCO Y OSCURO. AGITE EL BOTE ANTES DE USAR. PARA USO EXCLUSIVO EN LABORATORIO.
Peligro: Los dermatofitos son hongos de alto riesgo para el operario.
PREPARACIÓN, MODO DE EMPLEO E INTERPRETACIÓN DE RESULTADOS
Disolver 62 g en 1 litro de agua destilada. Calentar hasta ebullición para su completa disolución. Autoclavar a 115 ºC sólo 10 minutos. No sobrecalentar. Si se desea, añadir al medio enfriado a 55 ºC, 0,5 g/l de Cicloheximida (SKM200) esterilizada por filtración, para eliminar la mayoría de hongos saprófitos acompañantes. Agitar y dispensar en tubos dejados solidificar oblicuamente con el pico lo más largo posible, a fin de poder sembrar las muestras en superficie. Inocular asépticamente el escobillón, el raspado de piel o la arena, en superficie. Cerrar herméticamente el tapón e incubar a 22-25 ºC aproximadamente, durante 2-21 días. El enrojecimiento del medio desde las 48 h demuestra la presencia de hongos dermatófitos. Dejar crecer los micelios para poder identificar las especies al microscopio. Otros hongos no dermatófitos amarillean el medio.
COD: DMT033
PRESENTACIÓN: MEDIO DESHIDRATADO, TUBOS PREPARADOS HERMÉTICOS DE AGAR INCLINADO
CONTROL DE CALIDAD DEL MEDIO
Realizado en nuestro laboratorio; es prudente repetirlo en su laboratorio siempre que varíen las condiciones (más de 3 meses sin usar, tras desinfectar laboratorio, tras conservar a alta Tª, cuando adquiere aspectos extraños aunque no haya llegado la fecha de caducidad teórica de la etiqueta,…)
- DESHIDRATADO: Polvo fino, Amarillo
- PREPARADO: Crema-anaranjado
- CONTROL DE CRECIMIENTO 2-7 días a temperatura ambiente (21-28°C aproximadamente):
- Candida albicans MKTA 10231, Correcto, colonia blanca en 2-3 días.
- Thichophyton rubrum MKTC 2794, Viraje a rojo en 2-7 días.
- Penicillum chrysogenum MKTA 9478, Colonia verde en 3-7 días, Sin viraje.
- Aspergillus niger MKTA 16404, Colonia negra, en 3-7 días, Sin viraje.
A causa del gran poder infeccioso de estos hongos, lo ideal es cultivarlos en tubos herméticos fabricados con este agar inclinado con pico largo (Ref: TPL057).
DTM TAPLIN AGAR DERMATOFITOS PARA DETECCIÓN RÁPIDA DE ESTOS HONGOS DE LAS TIÑAS EN ARENAS DE PLAYAS, MASCOTAS, GRANJAS, UÑAS…
https://www.microkit.es/fichas/DERMATOPHYTE-DTM-TAPLIN-AGAR.pdf
El usuario es el único responsable de la eliminación de los microorganismos según la legislación medioambiental vigente. Autoclavar antes de desechar a la basura.
Si desea más información sobre nuestros MEDIO DERMATOPHYTE SELECTIVE CAF. AGAR rellene nuestro formulario de contacto http://www.medioscultivo.com/contacto . O si lo prefiere póngase en contacto con nosotros a través de nuestro correo electrónico microkit@microkit.es o por teléfono en el nº 91-897 46 16

Me interesa el precio del medio DTM 500 grs o presentación más chica
Hola, en qué pais estás? El precio depende mucho de eso. Si quieres escribe un email a microkit@microkit.es, que aqui no damos precios